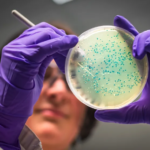
Paso 1: diagnostico de la enfermedad periodontal y plan de tratamiento

Las enfermedades de las encías
La gingivitis y periodontitis son la causa más común de la pérdida dental.
-Gingivitis: inflamación de los tejidos periodontales que rodean al diente pero es reversible y se produce por el acúmulo de restos bacterianos alrededor de la encía, ésta se inflama y sangra, aunque muchas veces el paciente fumador puede no presentar sangrado por efectos secundarios a la vasoconstricción.
-Periodontitis o piorrea: enfermedad crónica que afecta a los tejidos de sostén con destrucción y perdida del tejidos óseo su efecto es irreversible. Es de causa multifactorial (hereditaria, malos hábitos higiénicos, paciente fumador que agrava el pronóstico, enfermedades sistémicas no controladas: diabetes, osteoporosis…, mala posición dental , reconstrucciones mal adaptadas que favorecen el acúmulo de placa bacteriana).
En nuestra clínica dental tenemos 2 higienistas ampliamente formadas que realizaran las higienes con y sin anestesia en función de la sensibilidad dental y que os instruirán en mejorar vuestros hábitos higiénicos. Os explicaran mediante fantomas (modelos dentales) cómo debéis realizar el cepillado dental con cepillo manual y eléctrico y en el uso del irrigador dental (un instrumento fundamental para mejorar la higiene en los pacientes periodontales y pacientes que llevan implantes dentales ya que es una herramienta que ayuda a limpiar aquellas zonas donde el cepillo no limpia pero las bacterias si acceden).
El tratamiento periodontal consiste en la realización de raspados por cuadrantes para eliminar todo cálculo supra y subgingival y conseguir que las encías se desinflamen y no progrese la perdida ósea. El paciente periodontal requiere de un seguimiento y control periódico para conseguir estabilizar la enfermedad y mejorar su pronóstico.
Partes de un tratamiento periodontal
- Paso 1: diagnostico de la enfermedad periodontal y plan de tratamiento
Estudio de la microbiota mediante análisis bacteriológico si fuera necesario y periodontograma (estudio del sondaje de todos los dientes para valorar el grado de pérdida ósea).
- Paso 2: Fase higiénica
Consiste en la eliminación de todo el sarro supra y subginvival mediante el uso de ultrasonidos y curetas.
- Paso 3: Revisión y control en el tiempo
Control periodontal en función de cada paciente (de su grado de afectación, compromiso en medidas de higiene por parte del paciente, etc)

Licenciada en Odontología por la Universidad de Barcelona en el 2005. -Postgrado de cirugía Bucal por la Universidad de Barcelona 2007-2009. -Experiencia clínica de más de 19 años de experiencia en odontología general, periodoncia, implantología y cirugía bucal como especialidad. -Autora de varias publicaciones en revistas nacionales e internacionales. -Directora/ Operadora de instalaciones de radiodiagnóstico por la Universitat de Barcelona .
Una higiene dental es el tratamiento de elección para eliminar calculo o sarro por encima de la encía en pacientes que presentan gingivitis pero no periodontitis.
en pacientes con pérdida ósea de soporte requieren mantenimientos periodontales llamados raspados que son limpiezas supra y subgingivales con anestesia para confort del paciente asegurándonos que eliminamos todo el sarro que exista bajo la encía para controlar y frenar la pérdida ósea
Una higiene dental es el tratamiento de elección para eliminar calculo o sarro por encima de la encía en pacientes que presentan gingivitis pero no periodontitis.
en pacientes con pérdida ósea de soporte requieren mantenimientos periodontales llamados raspados que son limpiezas supra y subgingivales con anestesia para confort del paciente asegurándonos que eliminamos todo el sarro que exista bajo la encía para controlar y frenar la pérdida ósea
El signo mas precoz es el sangrado , espontáneo o al cepillado(siempre que el paciente no se fumador porque este lo enmascara).También el enrojecimiento, la hinchazón o la perdida de encía (retracción), el mal aliento o mal sabor de boca y la hipersensibilidad frente a estímulos térmicos sobre todo al injerir alimentos o bebidas frías. Conforma la enfermedad periodontal evoluciona se puede observar cambio en la posición dental (se pueden abanicar) o la aparición de movilidad en los dientes.
Las dos técnicas son buenas si se hacen correctamente. El cepillado manual es el más accesible y económico. El cepilllo eléctrico es de gran utilidad en casos de movilidad reducida.
La herencia genética agrava la enfermedad periodontal pero es la combinación de la genética con factores ambientales la que determina la aparición o no de la enfermedad periodontal.
Al no poder modificar la predisposición genética la única manera de prevenir y tratar la periodontitis es el control del biofilm bacteriano.